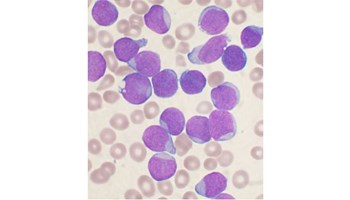
Científicos del Centro de Investigación del Cáncer desvelan cómo una lesión genética concreta impulsa la leucemia linfoblástica aguda B

Events

17/04/2026
Defensa de tesis doctoral: C3G in chronic myeloid leukemia: linking disease progression in mouse models with cellular leukemogenic mechanisms
Pablo Berrocal — Salón de actos del CIC

28/04/2026
Evaluating Next-Generation CAR-T Cells in Complex Tumor-Immune Models
Naiara Martínez-Vélez — CIC Lecture Hall
News

El Centro de Investigación del Cáncer participa en “New Health”, el proyecto que impulsa la innovación y los servicios avanzados en salud entre España y Portugal
El proyecto, dotado con 6,9 millones de euros, está dirigido a la creación de una plataf…

El CIC obtiene financiación de CNS2025 para terapias personalizadas contra el cáncer de vías biliares extrahepáticas
Javier Vaquero Rodríguez, investigador Ramón y Cajal del Centro de Investigación del Cáncer (CSIC-Universidad de…
Científicos del Centro de Investigación del Cáncer desvelan cómo una lesión genética concreta impulsa la leucemia linfoblástica aguda B
La leucemia linfoblástica aguda B es uno de los cánceres infantiles más frecuentes y…

Descubren cómo las mutaciones en el gen MYH9 dictan la gravedad de enfermedades raras de la sangre
Un consorcio internacional liderado por el Dr. Miguel Vicente-Manzanares, del Centro de Investigación del Cá…
















